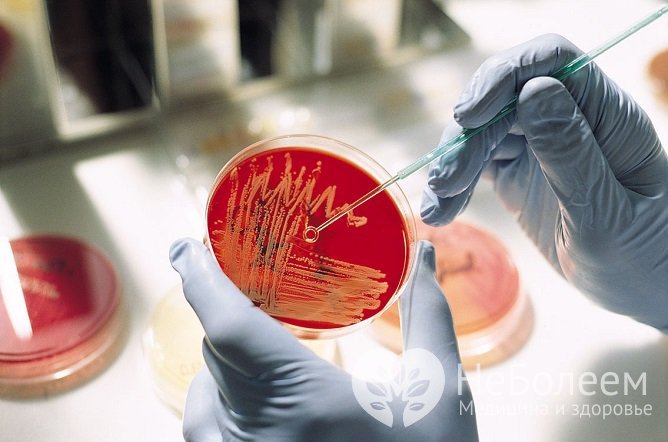
Бакпосев содержимого из уретры помогает определить причину уретриту у мужчин

Воспользуйтесь поиском по сайту:
Уретрит у мужчин
Содержание статьи:
Уретрит у мужчин – это воспаление слизистой оболочки уретры, или мочеиспускательного канала. Мужская уретра отличается от женской – она в несколько раз длиннее и имеет S-образный изгиб, это является причиной значительных различий в протекании уретрита у мужчин и женщин.
Уретритом чаще страдают мужчины молодого возраста.
 Уретрит у мужчин – это воспалительное инфекционное заболевание мочеиспускательного канала
Уретрит у мужчин – это воспалительное инфекционное заболевание мочеиспускательного каналаПричины уретрита у мужчин и факторы риска
Подавляющее большинство случаев воспаления мочеиспускательного канала обусловлено инфекцией, значительно реже встречается неинфекционный уретрит, причем неинфекционная форма уретрита может перейти в инфекционную.
В большинстве случаев инфекционный уретрит у мужчин обусловлен ИППП (инфекциями, передающимися половым путем). Кроме них, возбудителями инфекционного уретрита могут служить условно-патогенные микроорганизмы (стафилококки, кишечная палочка и пр.), активизирующиеся при снижении защитных сил организма.
Самой частой причиной уретрита у мужчин является заражение гонококком (Neisseria gonorrhoeae), в этом случае говорят о гонококковом уретрите. Возбудителями негонококковых инфекционных уретритов в большинстве случаев являются хламидии (Chlamydia trachomatis) и трихомонады (Trichomonas vaginalis). Кроме того, инфекционными агентами могут быть вирусы (вирус простого герпеса, аденовирусы и т. д.), грибки (Candida ablicans) и условно-патогенные микроорганизмы (кишечная палочка, микоплазмы и др.). Примерно в 30% случаев установить причину негонококкового уретрита не удается.
 Заражение гонококком – самая распространенная причина уретрита у мужчин
Заражение гонококком – самая распространенная причина уретрита у мужчинПредрасполагающими факторами воспаления уретры являются:
- незащищенные половые контакты с носителями инфекции;
- несоблюдение правил личной гигиены;
- травмирование уретры (в том числе во время проведения медицинских манипуляций);
- мочекаменная болезнь;
- застойные явления в органах малого таза;
- расстройства обмена веществ;
- переохлаждение организма;
- гиповитаминоз;
- нерациональное питание;
- аллергические реакции;
- раздражение уретры химическими веществами, содержащихся в средствах по уходу за телом, спермицидах, презервативах и пр.
Несвоевременное или неправильное лечение уретрита у мужчин опасно появлением серьезных осложнений: пиелонефрит, цистит, орхит, баланопостит, а также простатит.
Формы заболевания
В зависимости от причины уретрит у мужчин подразделяют на инфекционный и неинфекционный, а инфекционный, в свою очередь, на гонококковый и негонококковый.
Негонококковый уретрит разделяют на виды в зависимости от возбудителя:
- бактериальный (вызванный условно-патогенной микрофлорой);
- хламидийный;
- трихомонадный;
- микотический (кандидозный, грибковый);
- вирусный;
- туберкулезный;
- уреаплазменный;
- микоплазменный;
- гарднереллезный;
- смешанный.
Неинфекционный уретрит у мужчин бывает следующих видов:
- аллергический;
- травматический;
- застойный (конгестивный).
По длительности протекания болезни выделяют свежий (острый, подострый и торпидный) и хронический уретрит.
В зависимости от локализации патологического процесса:
- передний уретрит – в переднем отделе мочеиспускательного канала, т. е. расположенном ближе к выходному отверстию на головке полового члена;
- задний – в заднем отделе мочеиспускательного канала, т. е. локализуется ближе к мочевому пузырю.
Стадии заболевания
Свежий (острый) уретрит протекает в три стадии:
- Инкубационный период – время от момента заражения до начала заболевания, длительностью от 1-2 дней до 2 недель.
- Период выраженной симптоматики.
- Период реконвалесценции – полного выздоровления при благоприятных условиях (лечении) или хронизации процесса, т. е. перехода заболевания в хроническую форму в неблагоприятном варианте.
Следствием гонококкового уретрита у мужчин может стать стриктура (сужение) уретры. Хламидийный уретрит может послужить причиной развития синдрома Рейтера.
В клинической картине хронического уретрита также выделяют три чередующихся периода:
- Обострение (симптомы ярко выражены).
- Ремиссия (бессимптомное течение, однако воспалительный процесс не разрешен, он продолжается в неявной форме).
- Нестойкая ремиссия (скудные клинические проявления).
Симптомы уретрита у мужчин
Примерно в половине случаев уретрит у мужчин имеет латентное (скрытое) течение, когда симптомы либо вообще отсутствуют, либо имеют настолько невыраженный характер, что не обращают на себя внимания пациента. Первые выраженные признаки заболевания могут в этом случае проявиться через несколько месяцев (в ряде случаев – лет) от момента заражения.
Симптомами уретрита у мужчин являются рези, жжение и зуд при мочеиспускании, покраснение и слипание наружного отверстия мочеиспускательного канала за счет выделений, которые могут носить слизистый или гнойный характер, а также припухлость головки полового члена. Характер выделений зависит от возбудителя: гонорейный уретрит протекает, как правило, с большим количеством гнойных или гнойно-слизистых выделений, для кандидозного уретрита характерны слизистые выделения беловатого цвета, при иных формах уретрита выделения носят более скудный характер, в некоторых случаях могут отсутствовать вовсе (например, при воспалении мочеиспускательного канала вирусной природы). Мочеиспускания учащены, нередко отмечается болезненность при эякуляции, в моче и эякуляте иногда обнаруживаются следы крови. В случае острого течения заболевания страдает также общее состояние, появляются слабость, быстрая утомляемость, ломота в суставах и мышцах, повышается температура тела.
 Главный симптом уретрита у мужчин – резь, жжение и зуд при мочеиспускании
Главный симптом уретрита у мужчин – резь, жжение и зуд при мочеиспусканииВ отсутствие лечения через 1-2 недели от момента дебюта симптомы уретрита стихают, и заболевание переходит в хроническую форму. Для хронического уретрита у мужчин характерно волнообразное течение – периоды ремиссии сменяются обострениями. В период ремиссии проявления болезни отсутствуют, при обострениях появляются нерезкие боли по ходу уретры, незначительные выделения, а также болевые ощущения во время мочеиспускания и/или после него, болезненной может быть и эякуляция.
Читайте также:ТОП-7 самых распространенных венерических заболеваний
Диагностика
Проводится сбор жалоб и анамнеза, а также физикальный осмотр пациента. С целью уточнения диагноза назначают лабораторное обследование, в которое включаются:
- общий анализ крови;
- общий анализ мочи;
- бактериоскопическое исследование мазка содержимого уретры, окрашенного по Граму;
- бактериологический посев урогенитальных выделений;
- антибиотикограмма;
- полимеразная цепная реакция;
- иммуноферментный анализ;
- метод прямой иммунофлюоресценции и пр.
Бакпосев содержимого из уретры помогает определить причину уретриту у мужчин
Бакпосев содержимого из уретры помогает определить причину уретриту у мужчинВ большинстве случаев инфекционный уретрит у мужчин обусловлен ИППП (инфекциями, передающимися половым путем).
Лечение уретрита у мужчин
Лечение уретрита у мужчин проводится в амбулаторных условиях. В период лечения больным показана диета. Необходимо исключить из рациона острые, копченые, маринованные продукты, ограничить употребление соли, а также отказаться от приема алкоголя. На время лечения исключают половые контакты или, по крайней мере, используют барьерные методы контрацепции.
Медикаментозные препараты для лечения уретрита у мужчин подбираются в зависимости от вида заболевания. Инфекционный уретрит требует антибактериальной терапии (кроме вирусного – в этом случае антибиотики могут назначаться только при присоединении вторичной бактериальной инфекции). Для лечения свежего уретрита применяют, как правило, антибиотики широкого спектра действия, антибактериальная терапия хронического уретрита проводится с учетом чувствительности возбудителя (используются данные антибиотикограммы).
Независимо от того, какими были результаты анализов половых партнеров пациента, страдающего инфекционным уретритом, им также показана антибактериальная терапия.
При микотической форме уретрита используют системные противогрибковые препараты.
При неинфекционном уретрите аллергической природы применяют антигистаминные средства. При конгестивной форме уретрита необходимо выявить и устранить причину застойных явлений в малом тазу, на фоне которых развилось заболевание. При травматической форме уретрита может потребоваться хирургическое вмешательство.
Основное лечение может быть дополнено фитопрепаратами, обладающими противовоспалительным и мочегонным действием.
При хронической форме уретрита у мужчин широко применяется физиотерапия (магнитотерапия, лазеротерапия, УВЧ-терапия, электрофорез).
 Лечение уретрита у мужчин инфекционной природы проходит с применением антибиотиков
Лечение уретрита у мужчин инфекционной природы проходит с применением антибиотиковС целью укрепления иммунитета назначаются витаминные препараты и иммуномодулирующие средства растительного происхождения (препараты на основе эхинацеи, лимонника, женьшеня, элеутерококка колючего и пр.).
Продолжительность лечения уретрита у мужчин может варьироваться от одной до нескольких недель, в зависимости от формы и тяжести заболевания.
После проведенного лечения с целью оценки эффективности терапии следует пройти повторное диагностическое обследование.
Возможные осложнения и последствия
Несвоевременное или неправильное лечение уретрита у мужчин опасно появлением серьезных осложнений. Инфекционно-воспалительный процесс может распространяться на другие органы малого таза, приводя к развитию пиелонефрита, цистита, орхита, баланопостита, а также простатита, который, в свою очередь, способен стать причиной бесплодия и половых дисфункций.
Примерно в половине случаев уретрит у мужчин имеет латентное (скрытое) течение, когда симптомы либо вообще отсутствуют, либо имеют настолько невыраженный характер.
Следствием гонококкового уретрита у мужчин может стать стриктура (сужение) уретры. Хламидийный уретрит может послужить причиной развития синдрома Рейтера, который проявляется сочетанным поражением суставов, органов мочевыделительной системы и конъюнктивы.
Прогноз
При своевременной диагностике и адекватном лечении уретрита у мужчин прогноз благоприятный. При переходе патологии в хроническую форму, а также при появлении осложнений прогноз в отношении выздоровления снижается.
Профилактика
- Своевременное и адекватное лечение инфекционных заболеваний.
- Своевременное обращение к врачу при первых признаках, указывающих на возможное воспаление органов мочеполовой системы.
- Использование барьерных методов контрацепции во всех сомнительных случаях.
- Соблюдение правил личной гигиены.
- Отказ от вредных привычек.
- Укрепление организма: сбалансированное рациональное питание, избегание переохлаждения, регулярная, но не чрезмерная физическая нагрузка и т. д.
Видео с YouTube по теме статьи:
Об авторе

Информация является обобщенной и предоставляется в ознакомительных целях. При первых признаках болезни обратитесь к врачу. Самолечение опасно для здоровья!
Многие наркотики изначально продвигались на рынке, как лекарства. Героин, например, изначально был выведен на рынок как лекарство от детского кашля. А кокаин рекомендовался врачами в качестве анестезии и как средство повышающее выносливость.
























